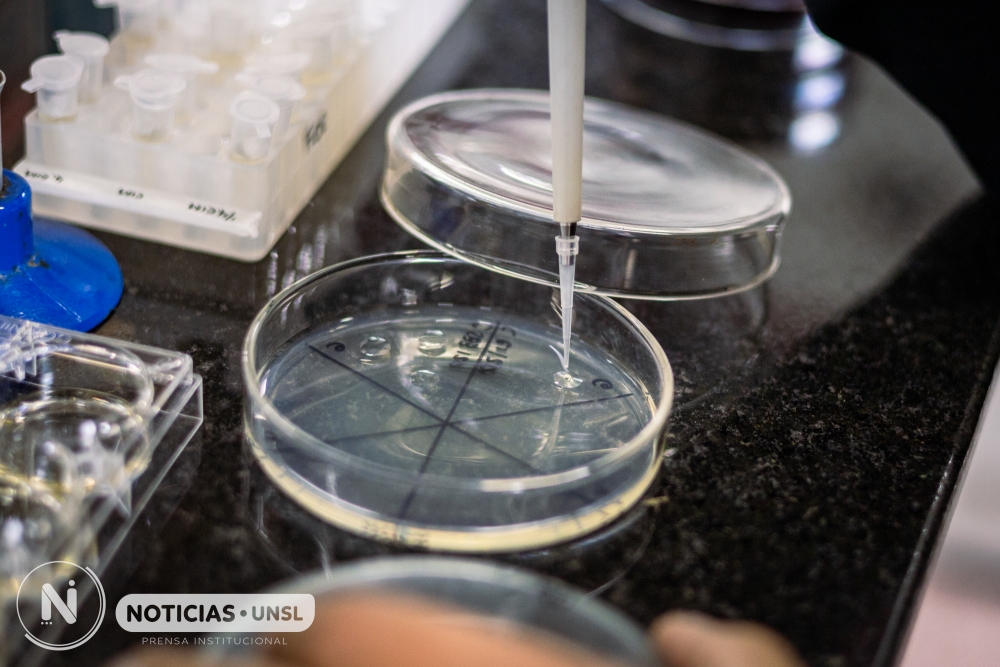

Se realizó el lanzamiento de la convocatoria pública del programa PROSUL Pepe Mujica, una iniciativa de cooperación científica y tecnológica entre Brasil y América Latina que cuenta con cuota reservada para universidades de la Asociación de Universidades del Grupo Montevideo (AUGM), representando una oportunidad directa para nuestra Institución.
El Programa busca apoyar proyectos de investigación colaborativa en seis (6) ejes temáticos estratégicos:
- Ambiente y sostenibilidad (cambio climático, biodiversidad, recursos hídricos, energías renovables).
- Alimentación y agricultura (seguridad alimentaria, biotecnología, sistemas resilientes).
- Energía y minería (transición energética, tecnologías limpias).
- Salud (enfermedades tropicales, vacunas, medicina personalizada).
- Tecnología de la información (inteligencia artificial, ciudades inteligentes, ciberseguridad).
- Ciencias humanas y sociales con énfasis en la región latinoamericana y caribeña.
Financiamiento disponible
Se dispone de un presupuesto global de R$ 50.000.000 (aproximadamente USD 10 millones), distribuidos en partes iguales entre becas y gastos operativos. Las propuestas pueden encuadrarse en tres (3) modalidades:
- Faja A – Redes temáticas de investigación consolidadas – Monto máximo: R$ 1.500.000
- Faja B – Redes temáticas de investigación emergentes – Monto máximo: R$ 600.000
- Faja C – Proyectos colaborativos bilaterales – Monto máximo: R$ 400.000
Es importante destacar que al menos el 10% de los recursos está reservado para proyectos que involucren instituciones de la AUGM, lo que representa una ventaja directa para las universidades argentinas miembro.
¿Quiénes pueden postular?
El/la proponente (coordinador/a del proyecto) debe:
- Poseer título de doctor/a.
- Tener Currículo Lattes actualizado a la fecha límite de presentación.
- Contar con vínculo laboral (relación de dependencia o estatutario) con una institución brasileña habilitada. En caso de estar jubilado/a, debe acreditar actividad académico-científica vigente y presentar declaración institucional.
- No registrar deudas ni incumplimientos con el CNPq ni con la Administración Pública Federal de Brasil.
Las propuestas deben incluir la participación de al menos una (1) institución de otro país latinoamericano o caribeño (Faja C) o de tres (3) o más países (Fajas A y B).
Se admite una única propuesta por postulante.
Cronograma
Cierre de presentación de propuestas: 18 de mayo
Presentación y consultas
Las propuestas deben enviarse exclusivamente a través de la Plataforma Integrada Carlos Chagas (PICC), disponible en línea. Para consultas, puede contactarse con el CNPq a través del formulario electrónico en su sitio web.
Para más información, se adjuntan el documento completo de la convocatoria y el documento de preguntas frecuentes (FAQ), ambos disponibles en portugués e inglés:
Texto completo de la convocatoria
Preguntas frecuentes
Contacto e información
interinstitucionales.unsl@gmail.com
266 4520300 interno 5298
2664759308
Oficinas de la Secretaría de Relaciones Interinstitucionales (SRI) ubicadas en edificio de Rectorado
Fuente: SRI
Foto: archivo Prensa UNSL